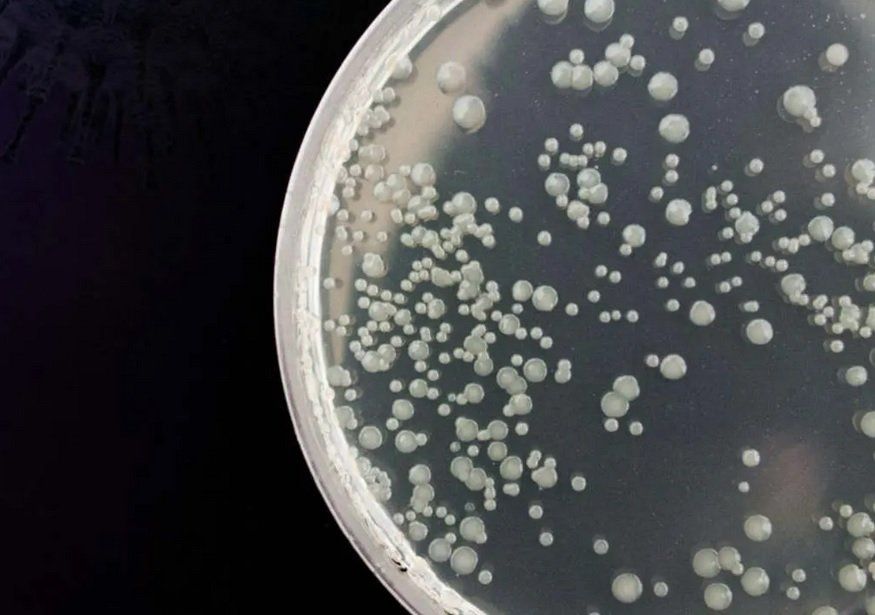

aktuelles / wissenschaft
Viren beherrschen unser Leben
Robert Koch Institut (RKI)
1.) Können Luftreinigungsgeräte bzw. mobile Luftdesinfektionsgeräte andere Hygienemaßnahmen ersetzen?
Generell ist das Risiko der Übertragung von SARS-CoV-2 im Nahfeld und bei längerem und engerem Kontakt am höchsten. Bei längerem Aufenthalt in z.B. kleinen, schlecht oder nicht belüfteten Räumen, in denen sich viele Personen aufhalten, kann eine Übertragung durch infektiöse, kleine luftgetragene Partikel (Aerosole) auch über eine größere Distanz als 1,5 m erfolgen. Solche Aerosole können am besten durch regelmäßiges Lüften bzw. bei raumlufttechnischen Anlagen durch einen Austausch der Raumluft unter Zufuhr von Frischluft (oder durch eine entsprechende Filtrierung) in Innenräumen reduziert bzw. entfernt werden (siehe auch „Welche Rolle spielen Aerosole bei der Übertragung von SARS-CoV-2?“).
Gegenwärtig werden als mögliche Maßnahme unterschiedlichste (mobile) Geräte angeboten, welche eine Reinigung bzw. eine Desinfektion der Raumluft erwirken sollen. Durch den Einsatz dieser Geräte soll eine Übertragung von SARS-CoV-2 in Innenräumen verhindert werden. Weitere Informationen zu den verschiedenen Techniken und Konzepten, z.B. dem Einsatz von Luftfiltern bzw. Vernebelungs- oder Strahlungstechniken, sowie zur Effizienz des Luftaustausches sind u.a. in der Stellungnahme “Das Risiko einer Übertragung von SARS-CoV-2 in Innenräumen lässt sich durch geeignete Lüftungsmaßnahmen reduzieren” des Umweltbundesamtes (UBA) zu finden. Die Kommission für Innenraumlufthygiene am UBA hat am 17.11.2020 zu Luftreinigern an Schulen Stellung genommen.
In diesem Zusammenhang ist es jedoch wichtig zu betonen, dass selbst eine effiziente Abreicherung (Reduzierung) von Aerosolen in der Raumluft das Risiko einer Übertragung im Nahfeld, z.B. bei face-to-face Kontakt bei einem Abstand von < 1,5 m nicht effektiv verringern kann. Darüber hinaus sind einige wichtige Fragen noch ungelöst, wie z.B. die tatsächliche Wirksamkeit bei der praktischen Anwendung, die gesundheitliche Unbedenklichkeit der eingesetzten Substanzen bzw. Verfahren oder die ausreichende Verteilung eines desinfizierenden Agens bzw. der gefilterten/desinfizierten Luft im gesamten Raum. Auch das Risiko einer indirekten Übertragung über (durch Tröpfchen) kontaminierte Oberflächen kann durch den Einsatz solcher Geräte nicht reduziert werden (siehe auch „Hinweise zu Reinigung und Desinfektion von Oberflächen außerhalb von Gesundheitseinrichtungen im Zusammenhang mit der COVID-19-Pandemie“).
Quelle:
https://www.rki.de/SharedDocs/FAQ/NCOV2019/FAQ_Liste_Infektionsschutz.html#FAQId14936962
Innenraumlufthygiene Kommission (IRK)
2.) Das Risiko einer Übertragung von SARS-CoV-2 in Innenräumen lässt sich durch geeignete Lüftungsmaßnahmen reduzieren
Die IRK macht deutlich, dass das Tragen einer Mund-Nasen-Bedeckung und die Einhaltung der Hygiene- und Abstandsregeln in Innenräumen nur dann ausreichend wirksam sind, wenn gleichzeitig für einen angemessenen Luftaustausch über Fensterlüftung oder Lüftungstechnik im Raum gesorgt wird.
Angemessen bedeutet in der derzeitigen Situation für eine möglichst hohe Zuführung von Frischluft zu sorgen, welche eine Innenraumluftqualität möglichst annähernd an die Außenluft herstellt.
SARS-CoV-2 stellt unsere Gesellschaft vor unerwartete und gänzlich neue logistische Herausforderungen. Mittlerweile haben wir erkannt, dass in unzureichend belüfteten Innenräumen das Risiko einer Ansteckung mit SARS-CoV-2 erhöht sein kann. Neben der Beachtung der allgemeinen Hygiene- und Abstandsregeln [1] und dem Tragen einer Mund-Nasen-Bedeckung kann dieses Risiko durch konsequente Lüftung und sachgerechten Einsatz von Lüftungstechniken in Innenräumen deutlich reduziert werden, auch wenn dadurch kein 100 prozentiger Schutz vor Infektionen mit SARS-CoV-2 in Innenräumen erreicht werden kann.
Quelle:
N-TV
3.) Luftreiniger schützen besser als Lüften
Wo Masken und Trennscheiben wenig nützen, können Luftreiniger das Risiko von Ansteckungen über Aerosole senken.
Eine Studie bestätigt, dass Luftreiniger mit entsprechenden Filtern das Risiko von Infektionen in Innenräumen deutlich senken können. Nicht nur ab der kalten Jahreszeit sind sie damit die bessere Alternative zum Lüften. Sie haben aber auch einen nicht zu unterschätzenden Nachteil.
Wissenschaftler der Universität der Bundeswehr in München (UniBw M) haben getestet, ob Luftreiniger in der Lage sind, Aerosole zu filtern und so das Risiko von Corona-Infektionen in Innenräumen zu reduzieren. Ihre Studie ergab, dass Geräte, die entsprechend ausgestattet sind, nicht nur effektiv die Virenlast in Innenräumen reduzieren, sondern auch oft wirksamer als das Lüften über geöffnete Fenster sind.
Dass Aerosole bei der Übertragung von Covid-19 in Innenräumen eine große Rolle spielen, ist in der Wissenschaft inzwischen nahezu unbestritten, zahlreiche Spezialisten gehen sogar davon aus, dass sie für die meisten Infektionen verantwortlich sind. Das ist vor allem problematisch für die Gastronomie, Kultureinrichtungen und Veranstaltungsorte, die deswegen gar nicht oder nur sehr begrenzt arbeiten können. Betroffen sind aber auch viele Büros und mit dem Ende der großen Ferien zunehmend Schulen.
Lüften wird im Winter schwierig
Im Sommer kann man lüften, um die Aerosol-Konzentration zu senken. Aber je kälter es wird, umso problematischer wird es, die Fenster oft und lange genug zu öffnen: Es wird Energie verschwendet, die Heizkosten steigen und die Menschen in den Räumen frieren. Außerdem ist es ohne Messgeräte kaum möglich, zu wissen, wann und wie oft gelüftet werden muss.
Für ihre Studie verwendeten die Wissenschaftler einen Luftreiniger, der bis zu 1500 Kubikmeter pro Stunde filtern kann, und analysierten seine Wirksamkeit systematisch mit Lasertechnik. Das Gerät verfügt über eine Filterkombination, mit der auch sehr kleine Aerosole mit einem Durchmesser von 0,1 bis 0,3 Mikrometer (µm) praktisch vollständig aus der Raumluft abgeschieden werden. Damit das Gerät selbst nicht zur Virenschleuder wird, kann man einstellen, dass der Filter alle 30 Minuten auf etwa 100 Grad erhitzt wird und so alle Erreger absterben. Den Forschern zufolge reiche es jedoch aus, diesen Vorgang einmal täglich durchzuführen.
“Anreicherung nicht möglich”
Laut Pressemitteilung der UniBw M ergaben die Ergebnisse, dass die Aerosol-Konzentration in einem Raum mit einer Größe von 80 Quadratmetern (m²) innerhalb von sechs Minuten halbiert wird. Bei einem Dauerbetrieb des Geräts sei daher die gemessene Verweilzeit des ausgeatmeten Aerosols im Raum sehr kurz, wodurch eine Anreicherung der Luft mit infektiösen Aerosolen nicht möglich sei. Eine ähnliche Effektivität maßen die Forscher in einem 22 Meter langen Flur mit rund 40 m².
Bei großen Räumen, solchen mit vielen Objekten oder sehr ungünstigen Geometrien seien gegebenenfalls mehrere Luftreiniger nötig, um alle Bereiche des Raumes zügig zu filtern und die Virenlast überall gering zu halten, schreiben die Wissenschaftler. Außerdem komme es auf den Standort an. So sollte der Luftreiniger möglichst an der längsten Raumseite in der Mitte positioniert sein. Außerdem sollten keine Objekte den Luftstrom Richtung Deckenbereich stören.
Effektiv, aber teuer
Die Bundeswehr-Forscher sehen nicht nur, dass Luftreiniger eine gute Alternative zum Lüften sind. Die Technik garantiere eine dauerhaft geringe Virenlast, was durch geöffnete Fenster oft nicht gewährleistet werden könne, schreiben sie. Auf Masken und Abstandsregeln könne aber nicht verzichtet werden, da immer noch die Gefahr einer direkten Ansteckung über Tröpfchen bestehe.
Die Wissenschaftler betonen, dass Luftreiniger auch in Schulen das Risiko von Ansteckungen durch Aerosole stark senken können. Allerdings kostet das für die Studie verwendete Gerät rund 3500 Euro. Dazu kommen Strom- und Wartungskosten. Für jedes Klassenzimmer ist ein eigener Raumluftreiniger nötig. Ob sich das viele deutsche Schulen leisten können, ist zweifelhaft.
Quelle:
https://www.n-tv.de/wissen/Luftreiniger-schuetzen-besser-als-Lueften-article21956743.html
N-TV
4.) Studie Aerosole sind Hauptübertragungsweg
Eine Analyse von internationalen Studien zum Coronavirus stützt Forschungen, die Aerosole als einen Hauptübertragungsweg von Covid-19 sehen. Ist die Hypothese richtig, müssen Schutzmaßnahmen für Innenräume überdacht werden, unter anderem für Klassenzimmer und Büros.
Schon Mitte Mai wies Virologe Christian Drosten darauf hin, dass Aerosole neben der Tröpfcheninfektion vermutlich der wichtigste Übertragungsweg für das Coronavirus seien. Dabei handelt es sich grundsätzlich ebenfalls um Tröpfchen. Sie sind aber mit weniger als 5 Mikrometern wesentlich kleiner und können in Partikeln über längere Zeit in der Luft schweben.
Seitdem verdichten sich die Hinweise darauf, dass Aerosole eine wichtige Rolle bei der Übertragung von Covid-19 spielen, es fehlen aber noch wissenschaftliche Beweise. Auch wenn sie diese nicht liefern kann, bestätigt eine zusammenfassende Analyse des US-Lungenspezialisten Kevin P. Fennelly aber die dominante Rolle von Aerosolen bei der Corona-Verbreitung. Sie wurde in der renommierten medizinischen Fachzeitschrift “The Lancet” veröffentlicht.
Aerosole gefährlicher als größere Tröpfchen
Fennelly hat verschiedene Studien zur Verbreitung von Viren über Partikel, die beim Husten und Ausatmen ausgestoßen werden, analysiert. Sein Ziel war es, herauszufinden, welche Masken und andere Maßnahmen Mitarbeiter im Gesundheitswesen vor einer Ansteckung mit Covid-19 schützen können.
Der Lungenarzt kommt zu dem Ergebnis, dass die Annahme, dass die meisten Atemwegsinfektionen über Tröpfchen stattfinden, nicht richtig ist. Krankheitserreger wie das Coronavirus würden von infizierten Personen zwar in verschieden großen Partikeln ausgestoßen, besonders viele Viren befänden sich aber in Aerosolen, die kleiner als 5 Mikrometer sind.
Daraus schließt Fennelly unter anderem, dass Krankenhauspersonal grundsätzlich mit Masken ausgestattet sein müssen, die Aerosole filtern können (FFP2/3). Außerdem sollten sie Schutzschilde tragen, um ihre Augen zu schützen. Doch seine Erkenntnisse spielen auch eine Rolle außerhalb des Gesundheitssystems. Denn wenn Aerosole tatsächlich eine wichtigere Rolle bei der Übertragung des Coronavirus spielen als eine herkömmliche Tröpfcheninfektion, ergeben beispielsweise die aktuellen Abstandsregeln keinen Sinn, wenn sich Menschen in Innenräumen treffen. Das ist beispielsweise der Fall, wenn nach den Sommerferien Schulen den Regelbetrieb wieder aufnehmen.
Dass Sars-Cov-2 in Aerosolen längere Zeit überleben können, legt unter anderem eine Studie nahe, die am 22. Juni im Journal “Emerging Microbes & Infections” erschienen ist. Britische Wissenschaftler hatten dafür unter anderem Aerosole aus künstlichen Speichel mit 2 bis 3 Mikrometern Durchmesser hergestellt und mit Coronaviren bestückt. Laut Spektrum.de konnten die Forscher lebende Viren sowohl bei hoher als auch bei niedriger Luftfeuchtigkeit noch nach 90 Minuten feststellen.
Wissenschaftler schreiben offenen Brief an WHO
Für Lidia Morawska von der Queensland University of Technology in Brisbane gibt es keine Zweifel mehr. Sie ist Mit-Autorin einer Analyse eines Superspreader-Events bei einer Chorprobe im US-Bundesstaat Washington. “Aerosolübertragung ist die einzige logische Erklärung für solche Infektionsgeschehen”, sagte sie Spectrum.de. Morawska verfasste einen offenen Brief an die Weltgesundheitsorganisation (WHO) und nationale Behörden, den 237 internationale Forscher unterzeichnet haben. Sie rufen die Organisation dazu auf, die Aerosolübertragung als Infektionsweg ernst zu nehmen und entsprechende Empfehlungen für die Belüftung und Dekontamination von Gebäuden auszuarbeiten. Die WHO hat immerhin angekündigt, die Forderungen ernsthaft zu überprüfen.
Das RKI hat die Bedeutung der Aerosolübertragung bereits weitgehend anerkannt. Im “Steckbrief” zu Covid-19 heißt es: “Der längere Aufenthalt in kleinen, schlecht oder nicht belüfteten Räumen kann die Wahrscheinlichkeit einer Übertragung durch Aerosole auch über eine größere Distanz als 2 Metern erhöhen, insbesondere dann, wenn eine infektiöse Person besonders viele kleine Partikel (Aerosole) ausstößt und exponierte Personen besonders tief einatmen.” Und: “Durch die Anreicherung und Verteilung der Aerosole ist unter diesen Bedingungen das Einhalten des Mindestabstandes gegebenenfalls nicht mehr ausreichend.”
Quelle:
https://www.n-tv.de/panorama/Studie-Aerosole-sind-Hauptuebertragungsweg-article21936242.html
Universität der Bundeswehr München, Institut für Strömungsmechanik und Aerodynamik
5.) Können mobile Raumluftreiniger eine indirekte SARS-CoV-2 Infektionsgefahr durch Aerosole wirksam reduzieren?
Übersicht
Die weltweite Entwicklung der SARS-CoV-2 Infektion verdeutlicht, dass die Pandemie erst am Anfang steht und nicht aufzuhalten ist. Selbst wenn ein wirksamer und gut verträglicher Impfstoff zur Verfügung stände, wäre eine umfangreiche Impfung der Weltbevölkerung zur Bekämpfung der Virusausbreitung nicht realisierbar. Es ist daher notwendig, technische Lösungen zur Eindämmung der Pandemie zu etablieren. Mund-Nasen-Bedeckungen sind inzwischen allgemein anerkannte technische Hilfsmittel, um die direkte Infektionsgefahr beim Atmen, Sprechen, Singen, Husten und Niesen zu verringern. Die indirekte Infektion über infektiöse Aerosolpartikel, die sich mit der Zeit im Raum anreichern, lässt sich mit Mund-Nasen-Bedeckungen nicht verhindern [5]. Dafür sind festsitzende partikelfiltrierende Atemschutzmasken erforderlich. Alternativ besteht die Möglichkeit die Aerosolpartikel im Raum mittels Filterung abzuscheiden oder über die Fensterlüftung abzuführen.
Raumlufttechnische Anlagen, die Aerosolpartikel mit einem Durchmesser kleiner 1 μm verlässlich abscheiden, sind selten. Das freie Lüften mittels Fenster ist oft nicht effizient und spätestens im Winter nicht mehr möglich ohne Energie zu verschwenden und die Gesundheit sowie das Wohlbefinden der Menschen zu gefährden. Die Frage ist daher, ob mobile Raumluftreiniger grundsätzlich geeignet sind, einen sinnvollen Beitrag zur Reduzierung der Infektionsgefahr zu leisten?
Quelle:
BGHW Berufsgenossenschaft Handel und Warenlogistik
6.) Was sollte vor der Beschaffung von Luftreinigern beachtet werden?
In den Medien wird immer wieder über die Möglichkeit berichtet, mobile Luftreiniger zum Schutz vor SARS-CoV-2-Viren einzusetzen. Zur Luftreinigung werden unterschiedliche Verfahren angeboten die teilweise auch miteinander kombiniert werden. Dazu zählen Hochleistungsfilter, UV-C-Strahlung und Plasmatechnik.
Bei der Wirksamkeit von Geräten mit Filtertechnik wird häufig auf eine Studie der Universität der Bundeswehr in München verwiesen. In dieser Studie konnte gezeigt werden, dass sich die Aerosolkonzentration durch den Einsatz von Luftreinigern mit Hochleistungsfiltern selbst in Räumen mit einer Fläche von 80 m2 je nach Volumenstrom in 6 ‒ 15 Minuten halbieren lässt. Ein solcher Wirkungsgrad kann allerdings nicht ohne weiteres auf die Verhältnisse in betrieblich genutzten Räumen übertragen werden. Zum einen wurde dies mit einem sehr leistungsstarken Gerät bei einem Volumenstrom im Bereich von 600 bis 1500 m³ Luft/Stunde erreicht. Zudem fand die Untersuchung in einem weitgehend leeren Raum statt. Die Reinigungsleistung in der Praxis hängt stark davon ab, dass die gefilterte Luft möglichst ungehindert durch den Raum strömen kann bzw. belastete Luft möglichst aus dem gesamten Raum angesaugt werden kann. Möbel, Trennwände oder anderes behindern eine gleichmäßige Durchlüftung. Auch durch Wärmequellen wie Menschen, PCs, Lampen oder anderes kann der Luftstrom abgelenkt bzw. in seiner Ausbreitung beeinflusst werden.
Ein kritischer Punkt ist die Reichweite, mit der Luft aus dem Raum angesaugt werden kann. Die Strömungsgeschwindigkeit der angesaugten Luft lässt bereits in geringem Abstand vom Gerät erheblich nach, so dass je nach Leistung des Gerätes nach einem Meter Abstand kaum noch Luftbewegung feststellbar ist. Wenn jetzt noch Stühle, Tische oder anderes Mobiliar im Raum stehen, wird das Ansaugen bzw. eine gleichmäßige Durchlüftung behindert.
Als Nachweis für die Wirksamkeit wird häufig auf die Filterleistung verwiesen, z.B. die Verwendung von H14-Filtern die gewährleisten, dass Aerosolpartikel mit einem Durchmesser von 0,1 bis 0,3 μm zu 99,995% aus der Raumluft abgeschieden werden. Ob das Gerät als Ganzes diese Reinigungsleistung bringt bzw. als Ganzes getestet wurde, ist aus den Beschreibungen nicht immer ersichtlich. Darüber hinaus gelten die Angaben nur für den Anteil der Raumluft, der durch den Filter hindurchgesaugt wurde. Deshalb sollten immer die Testprotokolle angefordert werden. Gleiches gilt für Luftreinigungsgeräte, die mit UV-C-Strahlung, Plasmatechnik oder anderen Dekontaminationsverfahren arbeiten oder Kombination solche Verfahren einsetzen. Auch hier ist zu beachten, dass die Wirksamkeit des Luftreinigungsgerätes als Ganzes nachgewiesen sein muss. Die Wirksamkeit von UV-C-Strahlung zur Dekontamination von Oberflächen ist nachgewiesen. Ob die UV-C-Strahler oder das Plasma ausreichen, um die vorströmenden Luftvolumen von mehreren Hundert Kubikmetern pro Stunde ausreichend zu dekontaminieren, ist für die Anwendung in der Praxis ausschlaggebend.
Es lässt sich festhalten, dass pauschale Aussagen zur Wirksamkeit von Luftreingungsgeräten nicht möglich sind. Neben den gerätespezifischen Kriterien muss auch die jeweilige Raumgestaltung und –nutzung berücksichtigt werden. Luftreiniger können zudem Schutzmaßnahmen wie Abstandhalten nicht ersetzen, da sie keinen Schutz gegenüber Tröpfcheninfektionen bieten. Zu berücksichtigen ist auch, dass Luftreinigungsgeräte den Austausch verbrauchter durch frische Luft nicht ersetzen können.
Quelle:
Informationen usw. können Sie unter: info@ap-petersdorff.de bekommen.